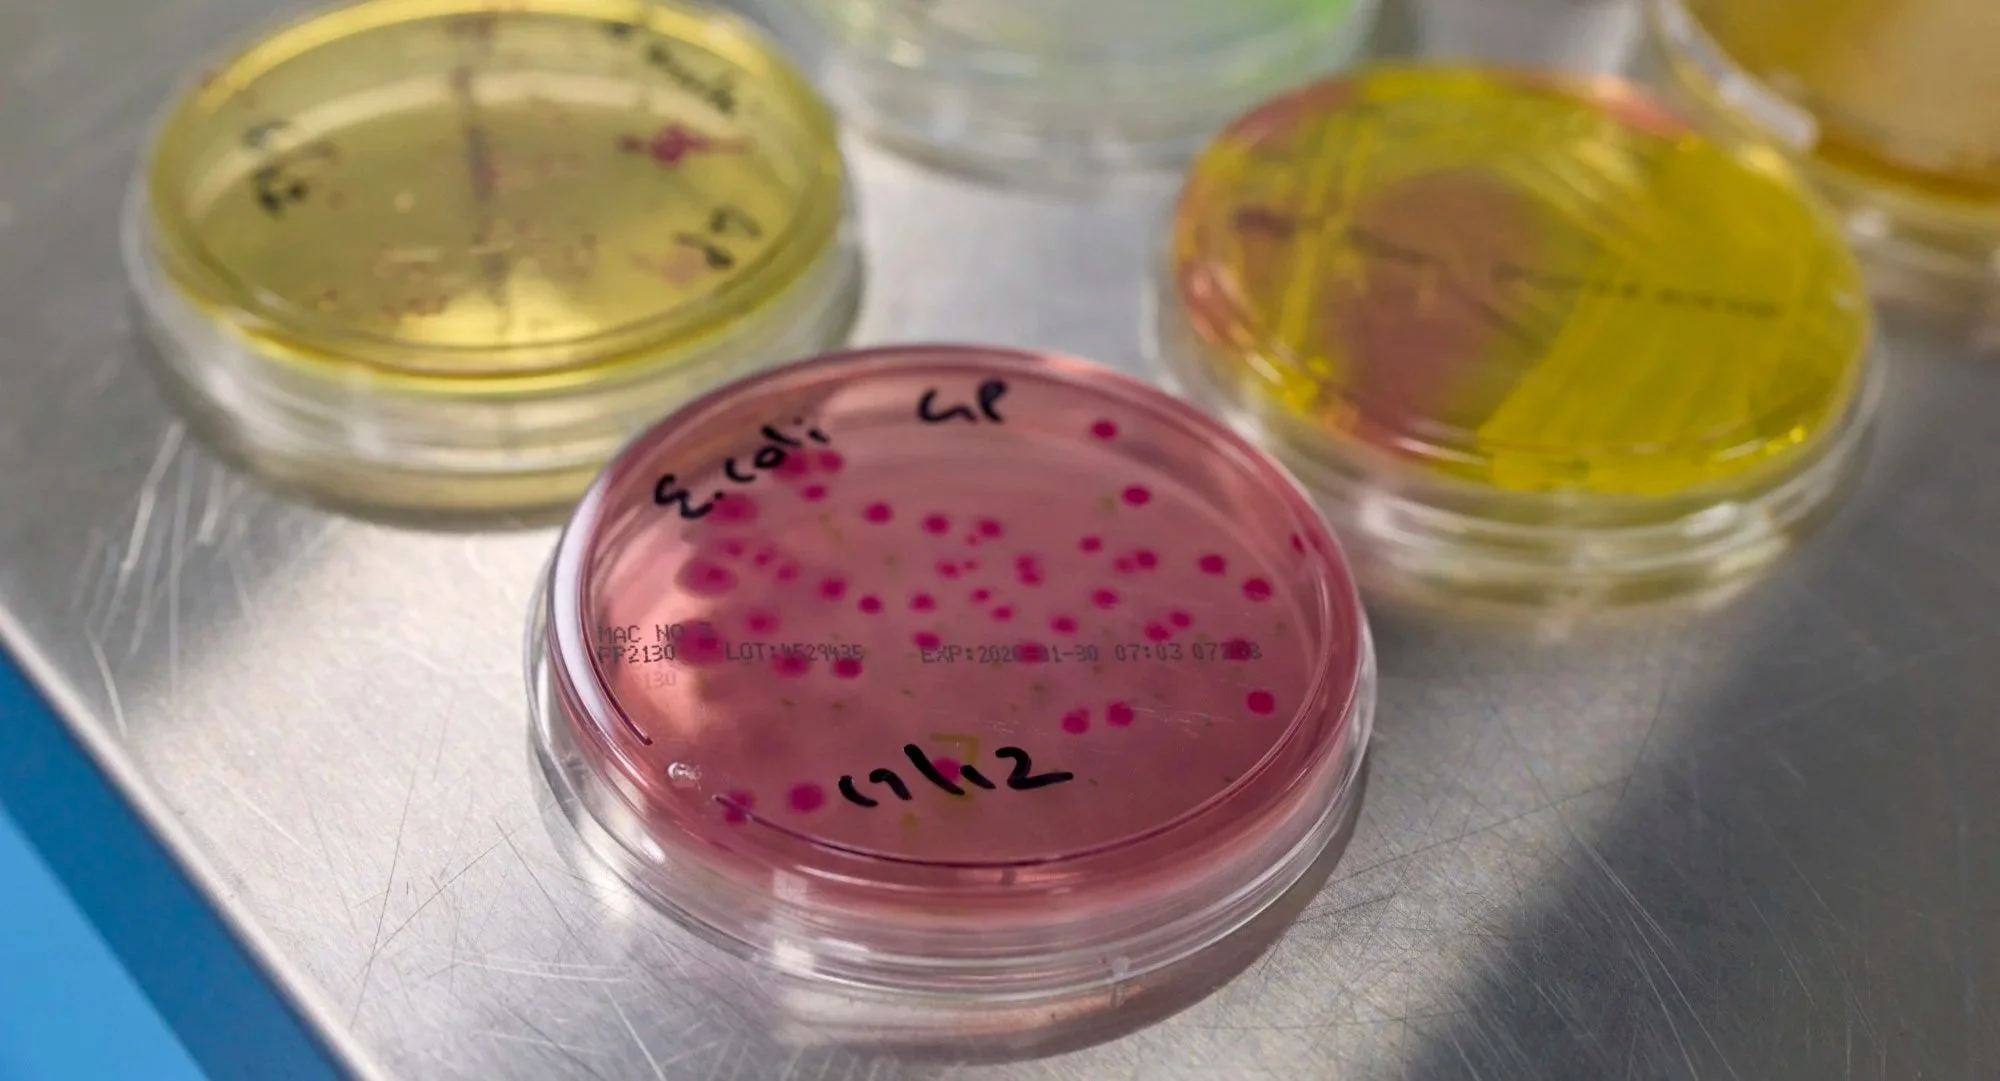

Our facility
Our purpose-built, state‑of‑the‑art facility:
Is TGA-licensed to code of Good Manufacturing Practice (cGMP) standards, enabling the delivery of products to international compliance standards and ensure patient safety
Leverages decades of expertise, with the facility design, construction, equipment and support systems specialised for small-run manufacture
Follows the latest PIC/S PE009 v17. Including containment with unidirectional flow and pass through rooms
Features flexible, scalable and modular clean rooms to adapt to the evolving client needs
Includes specialised centre-of-excellence suites for manufacture of sterile and non sterile (low bioburden) liquid products including labelling, packaging and storage
Houses an advanced microbiology testing laboratory equipped with cutting edge testing equipment
Holds Australia's first isolator technology using vaporised hydrogen peroxide (VHP) for contract manufacture and testing.
Is located in Melbourne’s south-east Biotech precinct, providing easy access to key research and biotech hubs as well as the airport



3 fit for purpose modular cleanrooms

1. Sterile facility
Filtration, aliquoting and capping in BioQuell isolator (decontaminated by VHP)
Dispensing and formulating in BioSafety cabinet
Terminal sterilisation also available
Licenced for clinical trial material fill-finish of liquid medicines for all phases (preclinical to Phase 3)
2. Specialty medicines facility

High volume automated groninger fill line with integrated labelling line
Licensed by the TGA, APVMA and other accredited departments. See full license list here
Labelling machine
Grade C and D cleanroom environments
3. Microbiology facility
Seperate facility for sterility testing, (VHP isolator and ScanRDI for rapid testing)
Tradition cleanroom for non-sterile testing






